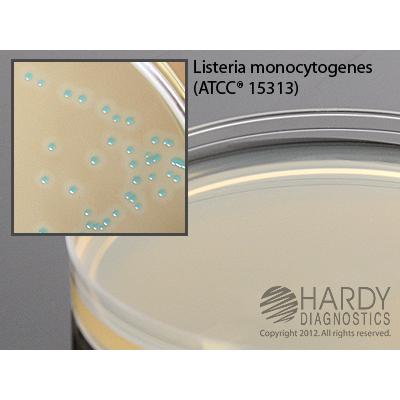

HardyCHROM™ Listeria, a chromogenic medium for Listeria monocytogenes, 15x100mm plate, Hardy Diagnostics
| Image | SKU | Description | Quantity | Price | Add to Cart |
|---|---|---|---|---|---|

|
G317 | HardyCHROM Listeria, 15x100mm plate | 10 Pack | $51 |
Description
HardyCHROM™ Listeria is a chromogenic medium recommended for the selective isolation, differentiation, and enumeration of Listeria monocytogenes from food and environmental samples by colony color and appearance. L. monocytogenes colonies will turn turquoise with a distinctive white halo.
Features
- Modified and improved ALOA formula
- Differentiates L. monocytogenes and L. ivanovii from other Listeria species
- Colonies turn turquoise with a white halo for easy read-out
- Results as early as 24 hours
- Economically priced
Summary
Listeria are gram-positive, non-sporing bacilli. They are ubiquitous in nature and can be isolated from soil, vegetables, and natural waters as well as from healthy animals and humans. While many species are non-pathogenic, Listeria monocytogenes is a well-established food poisoning risk. It can be found in uncooked meats and vegetables, as well as unpasteurized dairy products. Its ability to cause disease is due, in part, to the bacterium's ability to survive and grow at refrigerated temperatures. Clinical symptoms can range from flu-like illness to more serious conditions including meningitis, pneumonitis, septicemia and endocarditis. Listeria monocytogenes infections mainly occur in neonates, pregnant women, the elderly and immunocompromised individuals. Infections in pregnant women are a documented cause of spontaneous abortions and still births.
HardyCHROM™ Listeria is a chromogenic medium that allows for the rapid and reliable detection of Listeria monocytogenes. Current isolation methods for L. monocytogenes require multiple media types and can require up to 10 days of incubation. With HardyCHROM™ Listeria, there is only a single broth enrichment step for a total incubation time of 48-72 hours.
HardyCHROM™ Listeria contains specific chromogenic substrates that result in all Listeria species producing turquoise colored colonies when the substrate is hydrolyzed by specific enzymes. Further, this medium is able to detect the phospholipase activity specific to the two pathogenic Listeria species: L. monocytogenes and L. ivanovii. These two species will produce turquoise colored colonies surrounded by an opaque white halo within 48 hours. While L. ivanovii is rare in clinical samples, further tests are needed to definitively differentiate between these two species. Organisms other than Listeria are inhibited or grow as colorless or turquoise colonies without halos.
This media is to be stored and incubated in the dark.







